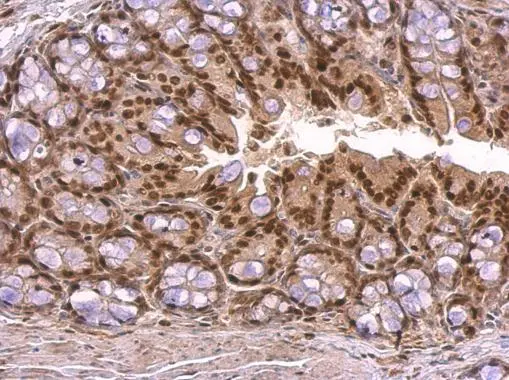
KLF4 antibody detects KLF4 protein at nucleus on mouse colon by immunohistochemical analysis. Sample: Paraffin-embedded mouse colon. KLF4 antibody (GTX101509) dilution: 1:500. 
 Antigen Retrieval: Trilogy? (EDTA based, pH 8.0) buffer, 15min

Non-transfected (–) and transfected (+) 293T whole cell extracts (30 μg) were separated by 10% SDS-PAGE, and the membrane was blotted with KLF4 antibody (GTX101509) diluted at 1:20000. The HRP-conjugated anti-rabbit IgG antibody (GTX213110-01) was used to detect the primary antibody.
KLF4 antibody
GTX101509
ApplicationsImmunoFluorescence, Western Blot, ImmunoCytoChemistry, ImmunoHistoChemistry, ImmunoHistoChemistry Frozen, ImmunoHistoChemistry Paraffin
Product group Antibodies
ReactivityHuman, Mouse
TargetKLF4
Overview
- SupplierGeneTex
- Product NameKLF4 antibody
- Delivery Days Customer9
- Application Supplier NoteWB: 1:5000-1:20000. ICC/IF: 1:100-1:1000. IHC-P: 1:100-1:1000. *Optimal dilutions/concentrations should be determined by the researcher.Not tested in other applications.
- ApplicationsImmunoFluorescence, Western Blot, ImmunoCytoChemistry, ImmunoHistoChemistry, ImmunoHistoChemistry Frozen, ImmunoHistoChemistry Paraffin
- CertificationResearch Use Only
- ClonalityPolyclonal
- Concentration1 mg/ml
- ConjugateUnconjugated
- Gene ID9314
- Target nameKLF4
- Target descriptionKLF transcription factor 4
- Target synonymsEZF, GKLF, Krueppel-like factor 4, Kruppel like factor 4, Kruppel-like factor 4 (gut), endothelial Kruppel-like zinc finger protein, epithelial zinc finger protein EZF, gut Kruppel-like factor, gut-enriched krueppel-like factor
- HostRabbit
- IsotypeIgG
- Protein IDO43474
- Protein NameKrueppel-like factor 4
- Scientific DescriptionTranscription factor which acts as both an activator and repressor. Binds the CACCC core sequence. Binds to multiple sites in the 5-flanking region of its own gene and can activate its own transcription. Required for establishing the barrier function of the skin and for postnatal maturation and maintenance of the ocular surface. Involved in the differentiation of epithelial cells and may also function in skeletal and kidney development.
- ReactivityHuman, Mouse
- Storage Instruction-20°C or -80°C,2°C to 8°C
- UNSPSC41116161

![WB analysis of mouse liver tissue lysate in (A) the absence and (B) the presence of blocking peptide using GTX17300 KLF4 antibody [4G6E11]. Working concentration : 1 μg/ml](https://www.genetex.com/upload/website/prouct_img/normal/GTX17300/GTX17300_2438_WB_20180221_w_23060620_389.webp)
![WB analysis of mouse liver tissue lysate in (A) the absence and (B) the presence of blocking peptide using GTX17306 KLF4 antibody [4E5C3]. Working concentration : 1 μg/ml](https://www.genetex.com/upload/website/prouct_img/normal/GTX17306/GTX17306_2439_WB_20180221_w_23060620_579.webp)